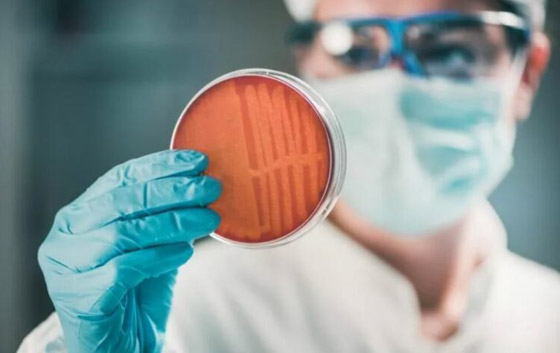
دراسة: 39 مليون شخص مهددون بالموت بحلول 2050! صورة رقم 1 دراسة: 39 مليون شخص مهددون بالموت بحلول 2050! صورة رقم 1

من المتوقع أن تصبح مقاومة المضادات الحيوية واحدة من أكبر الأسباب القاتلة لنوعنا البشري بحلول عام 2050، بحسب ما توقعته دراسة حديثة. وتنبأت الورقة البحثية بأن تقتل العدوى المقاومة للأدوية مئات الآلاف من البشر كل عام، ومع ذلك، فإن الحجم الحقيقي لهذه الكارثة بدأ للتو.
في دراسة هي الأولى من نوعها، حلل العلماء اتجاهات العدوى المقاومة للأدوية في جميع أنحاء العالم، وقدروا أنه في المتوسط، يموت أكثر من مليون شخص كل عام نتيجة لمقاومة مضادات الميكروبات (AMR) بين عامي 1990 و2021. ومن خلال استقراء هذه البيانات، قدر الفريق أن هذا الرقم قد يتضاعف تقريبًا بحلول عام 2050.
وقال دانييل أراكي، الباحث في معهد القياسات الصحية والتقييم وأحد المشاركين في الدراسة: "نقدر أن 39.1 مليون حالة وفاة تعزى مباشرة إلى مقاومة مضادات الميكروبات بين عامي 2025 و2050، مع وقوع العبء الأكبر على أفريقيا جنوب الصحراء الكبرى وجنوب آسيا".
وقال أراكي: "تشير التقديرات إلى أنه منذ عام 1990، ظلت مقاومة مضادات الميكروبات تمثل تهديدًا مستمرًا ومتزايدًا للصحة العالمية". وبالإضافة إلى الوفيات المباشرة، قدر الفريق أن مقاومة مضادات الميكروبات ستسهم في 8.22 مليون حالة وفاة سنويًا بحلول عام 2050، ارتفاعًا من 4.71 مليون في عام 2021.

أضاف: "على حد علمنا، هذا هو التحليل الأكثر شمولاً لاتجاهات مقاومة مضادات الميكروبات البكتيرية مع مرور الوقت، مع 23 مسببًا للمرض، و84 مجموعة من مسببات الأمراض، و11 متلازمة معدية في 204 دولة ومنطقة من عام 1990 إلى عام 2021. لقد سمح هذا النطاق الكبير بتقييم الاتجاهات المتغيرة في الوفيات الناجمة عن مقاومة مضادات الميكروبات لتحسين فهمنا لهذا التهديد الصحي المنتشر والمتزايد".

تابع: "تحليلنا للاتجاه الزمني يمكّننا أيضًا من توليد توقعات لإظهار التأثير المتزايد لمقاومة مضادات الميكروبات إذا لم تتغير الحوكمة العالمية وإظهار التأثيرات الضخمة التي يمكن أن تحدثها تحسينات الوقاية والرعاية والحصول على علاجات جديدة". لتلافي هذا الخطر، قدم أراكي عددا من النصائح، تمثلت فيما يلي: تحسين تدابير الوقاية والسيطرة، بما في ذلك زيادة التمويل والحصول على المضادات الحيوية واللقاحات الجديدة والمياه النظيفة والصرف الصحي.

أردف: "تحسين جودة الرعاية الصحية في المستشفيات والمراكز الصحية من خلال تعزيز القدرة التشخيصية، وتدريب القوى العاملة القوية في مجال الرعاية الصحية، وتنفيذ تدابير الوقاية من العدوى ومكافحتها، وإتاحة تدخلات جديدة للأفراد المصابين بأمراض متقدمة". أكمل: "زيادة مشاركة القطاعين الحكومي والخاص لتحفيز التمويل للمضادات الحيوية الجديدة وضمان وصول هذه الأدوية إلى السكان الذين هم في أمس الحاجة إليها".